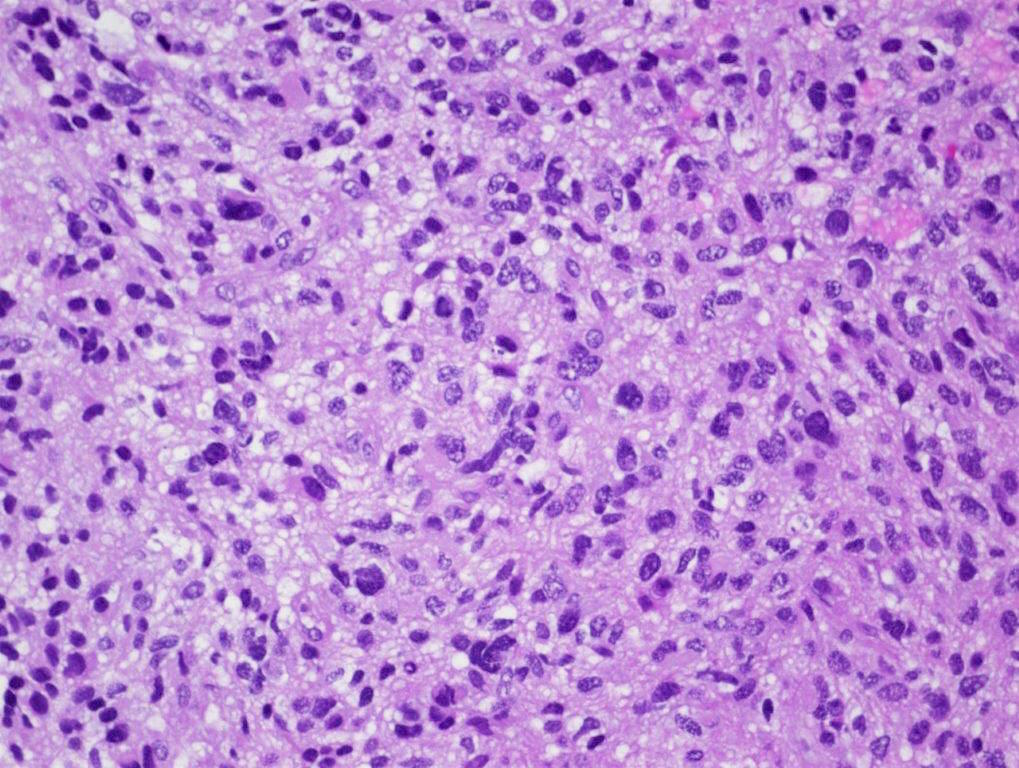

В начале февраля 2024 года в журнале Journal of Clinical Oncology вышло исследование, сообщающее об успешном применении нового экспериментального препарата ONC201 (дордавипрон) в лечении диффузных срединных глиом с мутацией H3 K27M.
Данный вид глиом отличается агрессивностью: наличие мутации гистона 3 (H3) K27M обуславливает низкую медиальную общую выживаемость - около 1 года после установления диагноза. На данный момент, помимо описанного в работе экспериментального лечения, не существует по-настоящему эффективной терапии таких опухолей.
Дондавипрон - это пероральный препарат, структурно представляющий собой "малую молекулу". Его механизм действия связан с двумя основными эффектами: он выступает в роли антагониста дофаминого рецептора D2/3 (DRD2/3) и аллостерического агониста митохондриальной протеазы - протеолитической субъединицы казеинолитической пептидазы митохондриального матрикса (ClpP).
Роль обеих этих мишеней уже была показана ранее в развитии глиом, а повышенная экспрессия DRD2 наблюдается в множестве различных опухолевых заболеваний, в том числе глиобластом.
Данный вид глиом отличается агрессивностью: наличие мутации гистона 3 (H3) K27M обуславливает низкую медиальную общую выживаемость - около 1 года после установления диагноза. На данный момент, помимо описанного в работе экспериментального лечения, не существует по-настоящему эффективной терапии таких опухолей.
Дондавипрон - это пероральный препарат, структурно представляющий собой "малую молекулу". Его механизм действия связан с двумя основными эффектами: он выступает в роли антагониста дофаминого рецептора D2/3 (DRD2/3) и аллостерического агониста митохондриальной протеазы - протеолитической субъединицы казеинолитической пептидазы митохондриального матрикса (ClpP).
Роль обеих этих мишеней уже была показана ранее в развитии глиом, а повышенная экспрессия DRD2 наблюдается в множестве различных опухолевых заболеваний, в том числе глиобластом.
Видео-презентация препарата:
Промо-материал опубликован фармацевтической компанией. Формат изложения информации может отклоняться от беспристрастного научного изложения фактов.
В упомянутой научной работе исследователи обобщают результаты пяти предшествующих клинических испытаний препарата на данных от 50 пациентов с диагнозом диффузной срединной глиомы с мутацией H3 K27M (46 взрослых и 4 ребенка).
Сообщается о сравнительно высокой эффективности препарата: доля общего ответа (overall response rate) согласно критериям RANO*-HGG** составила 20%, а согласно комбинированным критериям RANO-HGG/LGG** - 30%; медианное время достижения ответа (time to response) составило 8.3 месяца, длительность ответа (duration of response) - 11.2 месяца.
Стоит отметить, что препарат также показал неплохой профиль безопасности: только у 20% пациентов были отмечены нежелательные явления во время лечения (TR-TEAE) 3 степени (грейда), при этом наиболее частым НЯ стала утомляемость (у 10% пациентов). Ни НЯ более высокого грейда, ни летальных исходов или прекращения терапии отмечено не было.
Исследователи заявили об отличных перспективах применении данного препарата и о намерениях продолжать дальнейшее изучение препарата в клинических испытаниях на расширенных выборках пациентов.
*Response Assessment in Neuro-Oncology
**high-grade glioma, low-grade glioma
Сообщается о сравнительно высокой эффективности препарата: доля общего ответа (overall response rate) согласно критериям RANO*-HGG** составила 20%, а согласно комбинированным критериям RANO-HGG/LGG** - 30%; медианное время достижения ответа (time to response) составило 8.3 месяца, длительность ответа (duration of response) - 11.2 месяца.
Стоит отметить, что препарат также показал неплохой профиль безопасности: только у 20% пациентов были отмечены нежелательные явления во время лечения (TR-TEAE) 3 степени (грейда), при этом наиболее частым НЯ стала утомляемость (у 10% пациентов). Ни НЯ более высокого грейда, ни летальных исходов или прекращения терапии отмечено не было.
Исследователи заявили об отличных перспективах применении данного препарата и о намерениях продолжать дальнейшее изучение препарата в клинических испытаниях на расширенных выборках пациентов.
*Response Assessment in Neuro-Oncology
**high-grade glioma, low-grade glioma